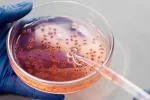
infecciones_y_virus

Artículo basado en la conferencia del Dr. Álvaro Franco, especialista en psiquiatría y en psiquiatría infantil, doctor en bioética de la Universidad El Bosque. Miembro correspondiente de la Academia Nacional de Medicina.
La clasificación de los trastornos mentales ha sido históricamente un proceso dinámico. En el siglo XIX, bajo la influencia del desarrollo de ciencias biológicas como la botánica y la zoología, surgió un interés por clasificar sistemáticamente las enfermedades. En este contexto, Emil Kraepelin propuso una de las primeras clasificaciones de los trastornos mentales, intentando organizar la diversidad de síntomas en entidades clínicas diferenciadas.
A mediados del siglo XX, el desarrollo de la psicofarmacología impulsó nuevas investigaciones y la expansión de categorías diagnósticas. Este proceso dio lugar a sistemas de clasificación como la Clasificación Internacional de Enfermedades (CIE) y el Manual Diagnóstico y Estadístico de los Trastornos Mentales (DSM). En sus primeras versiones (DSM-I a DSM-IV), predominó el modelo de “entidades discretas”, en el cual los trastornos se concebían como categorías claramente definidas, con criterios específicos para su diagnóstico.
Frente a la idea de que los trastornos son entidades separadas, surge el modelo de la continuidad o dimensional. Este plantea que los fenómenos psicológicos no se distribuyen en categorías cerradas, sino en un espectro continuo. Por ejemplo, la ansiedad no necesariamente constituye un trastorno en sí misma, sino que puede entenderse como el resultado de la acumulación de factores como el estrés, las pérdidas, las dificultades laborales o económicas. En este sentido, el límite entre la normalidad y la patología se vuelve difuso, dando lugar a las denominadas “zonas grises”.
Este enfoque también encuentra respaldo en la genética, donde no se identifican genes únicos responsables de trastornos específicos, sino múltiples factores de vulnerabilidad que pueden manifestarse de diversas maneras. En consecuencia, clasificaciones más recientes como el DSM-5 y la CIE-11 han incorporado la noción de espectro, como ocurre con el trastorno del espectro autista, reconociendo distintos niveles de funcionamiento y adaptación.
En la actualidad, se ha fortalecido el modelo dimensional, particularmente en la CIE-11, donde la psicopatología se entiende como una variación extrema de rasgos normales. Este enfoque se articula con una perspectiva de red, en la cual los trastornos no son entidades aisladas, sino el resultado de la interacción de múltiples factores biológicos, psicológicos y sociales.
A nivel clínico y administrativo, el diagnóstico sigue siendo necesario. Permite, por ejemplo, autorizar tratamientos, hospitalizaciones y construir perfiles epidemiológicos. En este sentido, los diagnósticos funcionan como herramientas prácticas que identifican síntomas predominantes dentro de un contexto específico, más que como descripciones completas de la persona.
Una de las propuestas contemporáneas más relevantes es el enfoque transdiagnóstico. Divide el diagnóstico en dos grupos: los trastornos internalizantes (caracterizados por la imposibilidad de exteriorizar las emociones) y externalizantes (asociados a la impulsividad y la conducta agresiva), además de otros como los trastornos psicóticos (que provocan una pérdida de contacto con la realidad), los somatomorfos (que se caracterizan por una preocupación excesiva y angustiante por síntomas físicos reales o imaginarios) y los de desprendimiento (que implican una desconexión entre la conciencia, memoria e identidad). Este modelo se vincula con el llamado “factor P”, que agrupa los factores de riesgo comunes a diversos trastornos.
Trastornos como la ansiedad o la depresión hacen parte de los del tipo internalizante. Una mirada integral del paciente revela historias complejas: experiencias de abandono, acoso escolar, conflictos emocionales previos y múltiples factores acumulativos. Se hace necesario entonces comprender a la persona más allá del diagnóstico, considerando su historia, contexto y proyectos de vida.
Los modelos actuales enfatizan la importancia de evaluar el grado de interferencia que los síntomas generan en la vida cotidiana, incluyendo el ámbito social, laboral y afectivo. Este enfoque permite una evaluación más ética, flexible y centrada en el sujeto, evitando la rigidez diagnóstica y favoreciendo la comprensión de la experiencia humana en su diversidad.
No obstante, persisten importantes desafíos éticos. Uno de ellos es la medicalización de la diferencia, es decir, la tendencia a considerar como patológicas variaciones normales del comportamiento humano. Ejemplos históricos, como la inclusión de la homosexualidad como trastorno hasta la década de 1980, evidencian cómo los diagnósticos pueden reflejar prejuicios sociales más que realidades clínicas.
Por otro lado, también existen intereses económicos y políticos que influyen en las clasificaciones. Algunos diagnósticos, como el trastorno por déficit de atención, presentan variaciones significativas en su prevalencia según el contexto cultural de los países. Está más presente en países con sobreexigencia, lo que plantea interrogantes sobre su naturaleza y clasificación.
Otro aspecto relevante es la falta de estabilidad diagnóstica. A diferencia de enfermedades médicas crónicas, los trastornos mentales pueden cambiar a lo largo del tiempo, e incluso una persona puede transitar entre estados de normalidad y psicopatología. Esto refuerza la necesidad de enfoques flexibles y dinámicos.
La clasificación de los trastornos mentales debe entenderse como una construcción histórica en constante evolución. Los modelos híbridos actuales, que combinan categorías y dimensiones, buscan equilibrar la utilidad clínica con una comprensión más amplia del contexto de los pacientes. No obstante, el reto principal sigue siendo evitar los extremos, o patologizar lo cotidiano o no dar importancia a determinados síntomas por considerarlos dentro de lo normal, dificultando así que el paciente reciba tratamiento.
La evaluación del paciente debe ser integral, considerando sus aspectos biológicos, psicológicos, sociales y culturales. Este enfoque permite una atención más ética y personalizada.
:::::::::::::::::::::::
Intervención completa en: FORO | LA EPIDEMIA SILENCIOSA: ANSI3D4D Y D3PR3SI*N
Nota. Victoria Rodríguez G. Comunicaciones Academia Nacional de Medicina
Visitas: 103